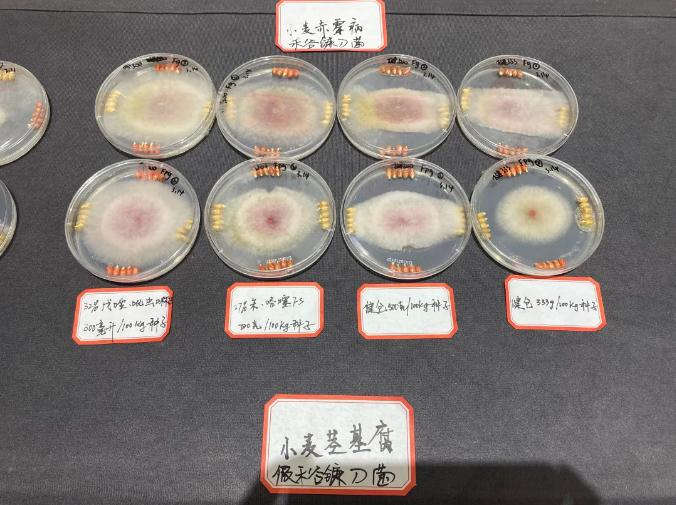

专利咪铜加持,健仓拌种市场再起
“专利咪铜加持,杀菌剂含量高,对小麦土传病害、花生根腐病等表现优异,上市7年累计推广面积超2500万亩……”3月19日,由安道麦辉丰(上海)农业技术有限公司主办的“龙行健仓®,大道丰收——健仓®小麦春季观摩及花生市场启动会”在河南省开封市盛大举办,会议对专利产品健仓®的产品价值和田间效果进行揭秘。

据了解,健仓®为30%嘧菌酯·咪鲜胺铜盐·噻虫嗪悬浮种衣剂,是安道麦专为大田(小麦、花生)市场重拳打造的一款专利种衣剂。从当天观摩情况来看,使用了安道麦健仓®方案的示范田,小麦叶色浓绿,长势健壮,根系旺盛,茎基部干净、粗壮,有效分蘖多,与市面主流竞品相比,防控小麦茎基腐病、纹枯病、根腐病等根茎部病害的效果更胜一筹。而健仓®方案在花生根腐病、白绢病的防控上,同样展现出较好的市场潜力。



李洪连教授介绍小麦茎基腐病及化合物筛选结果
“小麦茎基腐病被中国科协列为2022年十大产业技术问题!需要引起重视的是,小麦茎基腐病的优势病原菌假禾谷镰孢不仅危害茎基部,还可危害穗部,造成严重的穗腐病(赤霉病),我国每年因该病损失数十亿元!”河南农业大学植保学院李洪连教授指出,小麦茎基腐病属于土传病害,目前防治小麦茎基腐病,最有效的方法就是种子处理,同时辅以返青拔节期喷雾。试验表明,健仓®中的有效成分咪鲜胺铜盐对茎基腐病、赤霉病、根腐病等病原菌有很好的抑制作用,冬前苗期调查发现,健仓®拌种能显著降低小麦茎基腐病的发病程度;返青期调查发现,健仓®拌种能促进植株生长,在株高、根长和根鲜重方面均优于对照,对小麦茎基腐病仍然具有很好的防效。咪鲜胺铜盐与氟环唑可用于返青期茎基腐病、纹枯病等喷雾防治。
咪鲜胺铜盐是安道麦上海专利化合物,不仅杀菌谱广,活性高,用于种衣剂安全性更高,更加环保。对大部分子囊菌亚门、半知菌等真菌性病害都有较好的防治效果,铸就了健仓®优异的田间表现,成为小麦土传病害防控不可或缺的武器。

2021年,健仓®品牌焕新,重装上市,成为后续健仓®健康成长的重要基石。2022年,安道麦上海以河北、河南、山东为基础,举行了三省联动小麦测产会议,平均增产幅度达到了8%。2023年,面对小麦茎基腐病发生上行的趋势,安道麦上海积极与科研院所合作,进行小麦茎基腐病防治技术的联合探索,证实健仓®在小麦茎基腐病防治上防效优异。随着小麦茎基腐病、花生白绢病等土传病害的重发,健仓®正在迎来新的市场机遇。

小麦主要病害防控效果对比
“健仓®和市面上主流的种衣剂对比,杀菌剂的含量高,是一款性价比非常高的种衣剂产品,真正实现了种子包衣进行病虫害防治,最后达到丰产丰收的目的。”安道麦上海市场部种衣剂产品经理杜红亚在报告中指出,健仓®的产品特点和价值在于:

专利咪铜加持,展现巨大市场潜力
一是三元混配,专利咪铜加持。咪鲜胺铜盐用于种衣剂,安全、广谱、持效期更长,与常规种衣剂相比,不但安全性高,还大大增加了对于茎基腐病、根腐病的防治效果。
二是选用进口乳化剂、分散剂、成膜剂,色浆粒径纳米级,质量更稳定,对种子更友好,大大增强了种子包衣后的安全性。
三是种子包衣均匀度高,能够全方位的保护种子,避免病菌的侵染,实现苗期长久持效的呵护,农户使用以后会更加的省心。
在推广中,安道麦通过不断的优化和升级,摸索出了一套有效控制小麦茎基腐病发生蔓延的方案:苗前使用健仓®种子包衣,返青拔节期使用安道麦福满门®(12.5%氟环唑SC)或者福满美®(40%咪铜·氟环唑SC)进行叶喷,可以有效地遏制小麦茎基腐病以及一些其他根茎部病害的扩展蔓延,减少因根茎部病害导致的小麦枯白穗病害的发生,降低产量损失。

健仓®在花生市场同样具有广阔推广前景
郑州宇良农业科技有限公司总经理邓建社在总结中指出,健仓®是差异化专利种衣剂,市场前景广阔。近几年河南花生种植过程中,根腐病、白绢病、青枯病、蛴螬等病虫害趋于严重发生,市场机会凸显,将助推健仓进一步发展,实现科技惠农,助力农户丰产增收。

花生主要病虫害防控效果对比
健仓®上市7年过程中,安道麦上海通过品牌转化,制剂优化,与科研院所联合试验,组合方案升级等方式不断应对市场变化,为更好的解决小麦、花生不同细分市场的病虫害靶标而进行努力,通过种子包衣技术帮助更多的种植户实现苗期病虫害管理,助力粮食丰产丰收。
游客可直接评论,建议先注册为会员后评论!

以上评论仅代表会员个人观点,不代表中国农药网观点!



